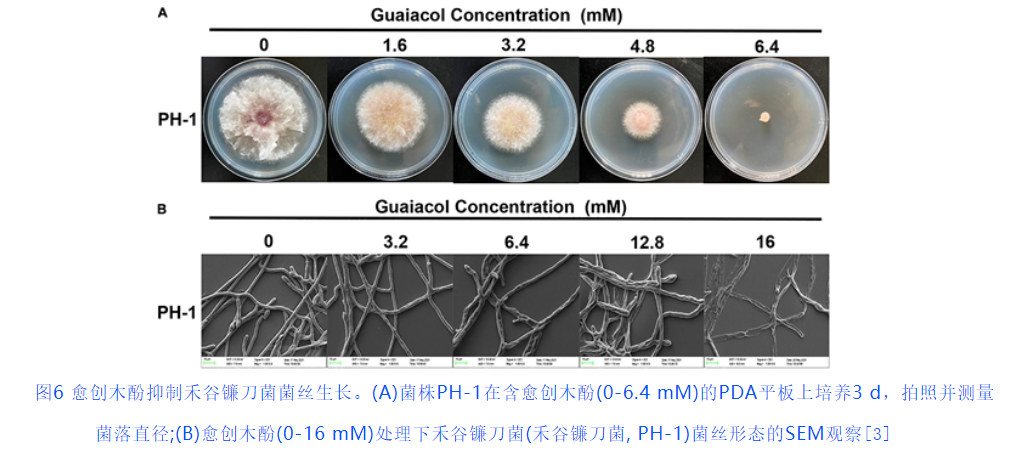

【多妈团购 美国Breathy布雷辛 舒痔清痔疮膏赠送独立导头】有“痔”人士赶紧冲,内痔/外痔/混合痔,不痛不痒一抹搞定,杜绝反复发-美初
| 运费: | 免运费 |
| 库存: | 305 件 |
商品详情
【多妈说】
都说十人九痔,小毛病发作起来还是很要命的
朋友就老是让我打听哪里有好用的痔疮膏
我是终于找到了~有痔人士闭眼入
去年就一直在打听,问供应商寄了很多样品
都给朋友试过了 还是这款最好使
~
也是亲测好用的了
朋友说没用一星期呢,肉球都扁下去不少了
市面上很多痔疮膏都仅有缓解作用,没法根治
而且这个是很容易复发的
真的可以试试它,从根源解决问题
涂上去是凉凉的,白色膏体,不怕弄脏裤子
预防复发。抗菌杠杠的~
长在私密部位有些人都宁愿忍着也不愿意去医院看
经常坐着站着久了就容易长
有些哪怕是做了手术也还会复发
甚至很多学生都有,其实坚持用它就可以
效果快,试了就知道了
我朋友这次又拍回去6支了!
拍一支里面带三个导头,内痔也可以用的
家里有长痔疮真可以试试它!


俗话说,「十人九痔」,可见有“痔”人士的广泛性
虽说它是个常见的小毛病,但真难受起来,也是相当要命的!
内痔出血外痔疼,混合痔更是让人崩溃🩸
排便不敢用力,有时坐着都会觉得硌得慌!别
担心!👉美国Breathy舒痔清 帮你轻松搞定!!
独家靶向抑菌科技,11种精研成分,强力渗透,直击痔核,
修护组织,长效预防!
一天两次,源头解决痔疮问题,从此不再反复😍

⭐真人实测!实验数据真实有效!
180位受痔困扰者临床测试结果显示👇
连续使用4周:出血情况好转98%,坠胀感减少97%瘙痒不适减
少96%,肉球减小93%!!!
简而言之,Breathy舒痔清针对内痔、外痔、混合痔效果显
著!!

Breathy舒痔清采用微分子渗透技术和独家靶向抑菌科技
将它抹在患处,微小分子能够强力穿透脂质包膜
直达痔核迅速释放药效,减少瘙痒和又肿又痛不适
随后能够快速破坏细菌细胞膜,阻断菌体繁殖
从而达到杀菌效果同时营造良好治愈环境,加速创口愈合修护并
能形成天然抗菌屏障,预防痔疮复发!


它的效果可不是咱们随口说的
⭐来,上权威国际认证的杀菌检测报告↓
报告数据显示:Breathy舒痔清抑菌率高到99.9%!!
效果真实有效,有“痔”人士放心用!!

根据痔疮严重程度,Breathy推荐↓
👉轻度痔疮:有瘙痒和疼痛,充血和肿胀等症状
坚持1盒/疗程,能够明显感受到“菊”部改变
👉中度痔疮:有肉球脱出,肛裂便血等症状
坚持2盒/疗程,能够消掉肉球,避免血便肛裂
👉重度痔疮:有肉球赘出,反复痔疮等症状
坚持4盒/疗程,根源除痔,长效抑菌,避免反复!

原来因为痔疮,上个厕所都提心吊胆的
用了一段时间后,痔疮再也没犯过!!
正巧好姐妹和我吐槽体检发现内痔火速就把
Breathy舒痔清推荐给了她前两天给我发消息,说是去复查了,发现内痔
消失了

推出后更是获得了美国消化病学会颁发
的AGA创新消化健康研究奖
国际肛肠健康促进协会颁发的杰出肛肠治疗创新奖
更是成为了德克萨斯医疗中心(Texas Medical Center)指定身体护
理用品!


在欧美超商卖$19.6/支(约143人民币),几乎不打折
咱们这次直接和品牌方对接,才要到一批优惠特惠开团骨折价:
1支仅需💰49,2支仅需💰79!!
活动数量有限,售完不补,刷到一定要囤!!

痔疮可以算是咱们身边最常见的肛肠疾病了
不论男女老少,全都属于高发人群!
“菊”部疼痛难忍,还可能伴有灼热感
还会有一些分泌物出现,导致周围的皮肤瘙痒异常
排便时“肉球”可能会脱出,还伴随着出血
各种问题层出不穷,怎么都摆脱不了……


中华中医药学会肛肠分会曾开展过关于肛肠疾病
调查结果显示,我国18周岁以上的居民肛肠疾病患病率高达50.1%
其中痔的患病率为49.14%而痔患病人数更是占所有患肛肠疾病人数的98.09%!!!
究其原因,辛辣饮食,久坐久站,不良排便习惯
长期腹泻或便秘,怀孕分娩等因素,均会诱发痔疮😱

由于外部的压迫和粪便的刺激
直肠下端的静脉丛会充血
或有淤血
久而久之就肿大形成了痔疮“肉球”
根据这些“肉球”的生长位置,分为内痔、外痔和混合痔
👉内痔,在肛门内,一般看不到
👉外痔,在肛门外,可直接看到
👉混合痔,同个痔块肛门内外均有

由于痔疮长在私密部位
很多人宁愿强忍着疼痛流血等不适也不愿去问诊治疗
时间一长,肉球越来越大,疼痛感也越来越强
不仅影响日常坐卧行走,还会导致睡眠
和肛周脓肿、肛瘘、肛周湿疹和括约肌功能下降等问题!!


所以,如果你也是有“痔”人士,千万别拖!
一定要抓紧时间去解决它!!!
但市面上大部分去痔产品
仅有暂缓和止痛作用,无法根除痔疮问题
医疗手术虽能去除肉球,但手术风险高
术后恢复期长,护理不好很可能会复发

想要快速高效解决痔疮困扰,预防后续复发
那就试试这款Breathy舒痔清!
11种精研成分,4步断痔消球快速缓解不适,
直达病灶消除痔核,形成屏障,持续防护一天两次,
从根源消除痔疮问题,杜绝反复发作!
有了它,再也不用担心痔疮困扰~




✅第一步:消除肿和痒,快速缓解不适
👉薄荷油、金合欢提取物
🌈薄荷油外用能麻醉神经末梢
而金合欢提取物作为一种天然类黄酮化合物,
具有优异的抗炎活性两者结合作用下,
缓解灼热不适,带来清凉舒缓的体验!




✅第二步:消除痔核,精准渗透,直达病灶
👉槲皮素、愈创木提取物、仙人掌提取物
🌈通过微分子渗透技术,有效成分直达病变部位
深入修复受损血管组织
并缩小痔核,减少痔疮复发的根源!
能够精准靶向,软化痔核,充血与肿胀也能缓解

✅第三步:促进愈合,修复组织,形成屏障
👉胶原蛋白肽、羊毛脂、库拉索芦荟凝胶
🌈羊毛脂具有极强的保湿作用
帮助形成保护层,锁住水分避免痔疮区域干裂
库拉索芦荟凝胶提供丰富的天然活性成分
胶原蛋白肽帮助修复皮肤组织,促进细胞再生,维持皮肤湿润
能够深层修复,舒缓保湿,加速组织愈合,形成天然保护屏障!
让肛周肌肉恢复原有的弹性!






✅第四步:预防复发,长效抗菌,持续防护
👉蜂胶提取物、天蚕素抗菌肽、脱乙酰甲壳素(又名壳聚糖)
🌈三大抗菌成分在患处形成天然抗菌屏障有效抑制细菌滋生,防止感染
复发并提升局部免疫力,保持长效保护,减少痔疮的反复发作






多重植物精粹和抗菌成分联合作用温和断痔,安全放心!
且这款Breathy舒痔清无药物依赖及敏感成分
0色素、0酒精、0荧光剂、0防腐剂、0激素、0矿物油!
就算是肌肤敏感人群也能放心大胆地用!!!


除了优质的成分配方
Breathy舒痔清的器型设计也相当用心!
采用了加深独立导入头,再深的内痔也能从容应对
加上医用卫生级灭菌袋独立包装
干净卫生,避免细菌污染!
再加上3CM人体工学长度,管体光滑,避免二次污染!


针对不同类型的痔疮,使用方法也略有不同
👉内痔:将导入器推进肛门1-2cm处,挤出膏体涂敷在患处
👉外痔、混合痔:将膏体直接涂抹在患处
另外,Breathy建议:每天早晚各1次,严重者可以1天
多次小伙伴们可以根据自己的痔疮情况来增减使用次数哦!

Breathy舒痔清是来自美国专注健康科学研究的机构Breathy(布雷辛)
旗下拥有10W级无菌车间和上百研发人员
所生产的产品均获得美国FDA和GMP双认证!
产品品质有保障!

痔疮问题不用愁,快把Breathy舒痔清用起来!
简单四步,源头解决痔疮问题,菊花立马洁净舒服!
每天抹一抹,去痔除根,还能预防复发!
“菊”部疼痛难忍的有“痔”人士,趁着开团特惠
赶紧多囤几支!!!


【产品名称】Breathy金合欢愈创木胶原蛋白膏
【规格】20g/支
【产地】美国
【生产日期】2025/2/14
【保质期】3年
【发货快递】三通一达随机发货
【发货时效】48-72小时
【不发货地区】港澳台不发货
【加运地区】新疆西藏+10
【适用场景】内痔、混合痔引起的肛门坠胀痛、黏膜充血、便秘等症状
【储存方式】请置于阴凉干燥处,避免阳光直射
【注意事项】
1.开封后请尽快使用,本品性状发生改变时禁用。
2.本品仅为外用膏,不得内服,不能代替药品,至于儿童不能触
及处。
3.儿童须在成人监护下使用:
4.请先清洁患处及其周边再使用本品。
5.请避免接触眼睛。如不慎入眼,请立即用清水或温水清洗并立即接受眼科医生的诊断和治疗。
6.如发生过敏,立即停止使用。
- 多妈柔软铺子 (微信公众号认证)
- 我是多妈,这家店命名叫多妈柔软铺子,是希望每个来到这里的你都能获得温暖柔软的体验和感受,如生活般美好,爱生活也要爱自己~
- 扫描二维码,访问我们的微信店铺
- 随时随地的购物、客服咨询、查询订单和物流...